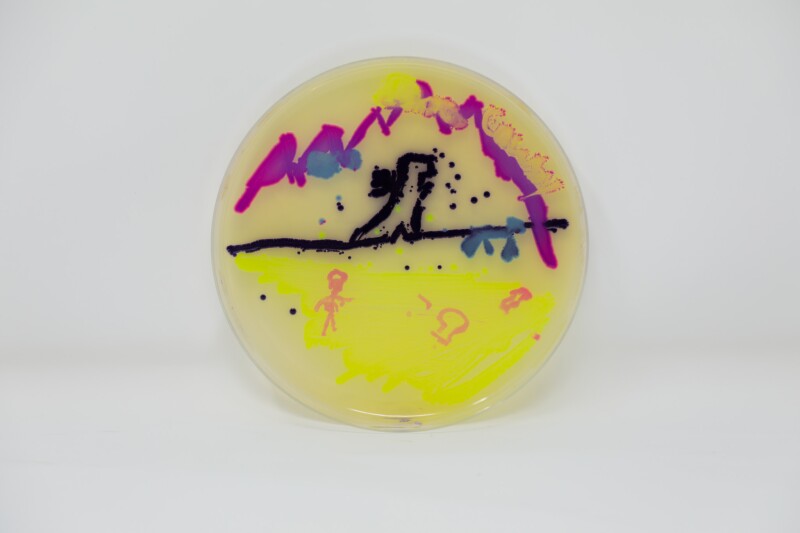
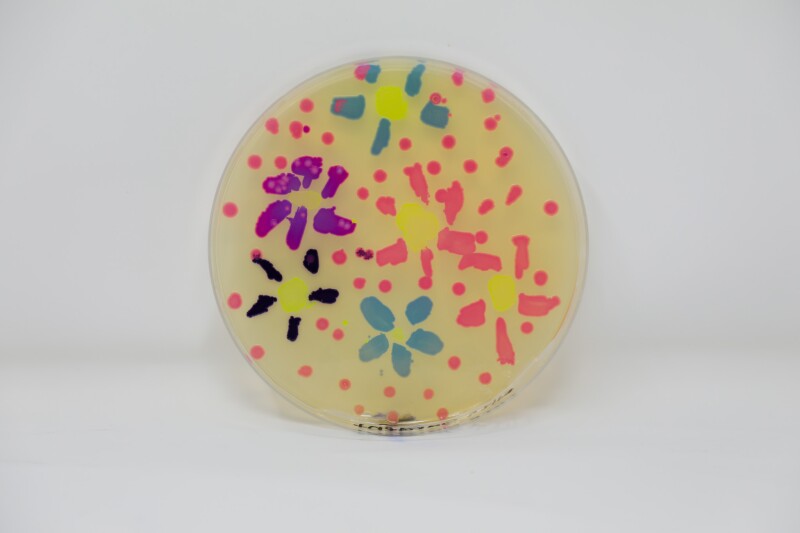
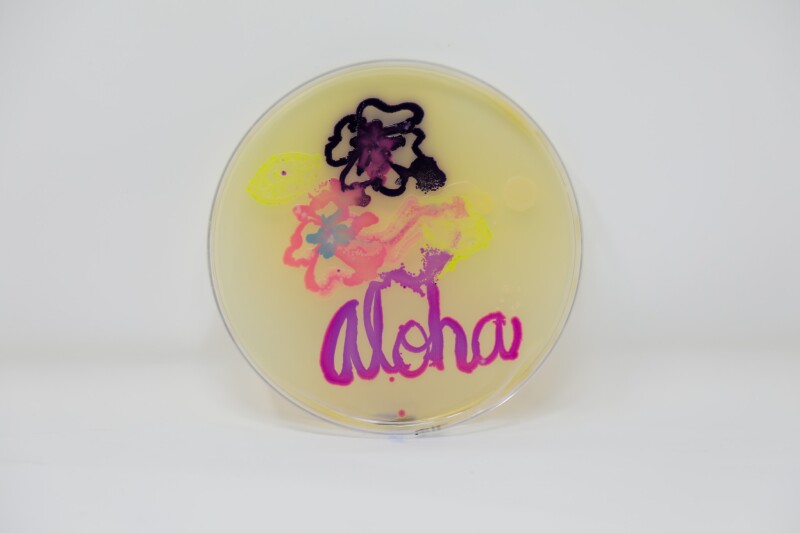
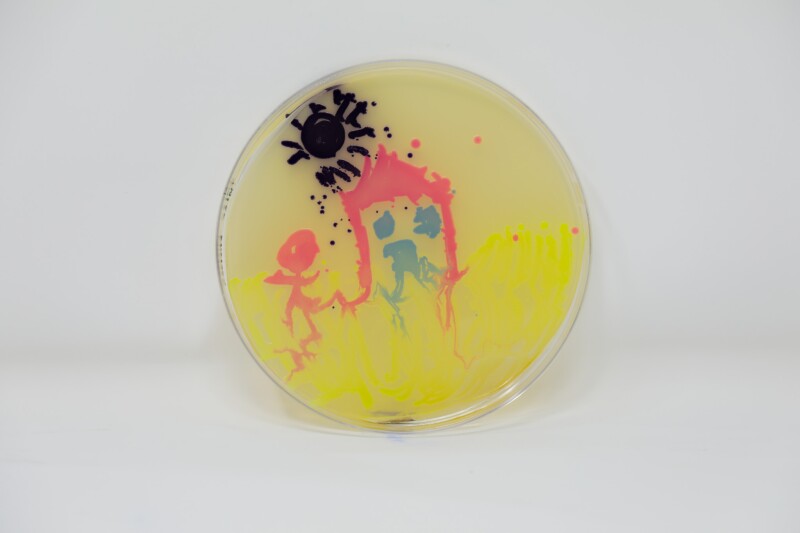
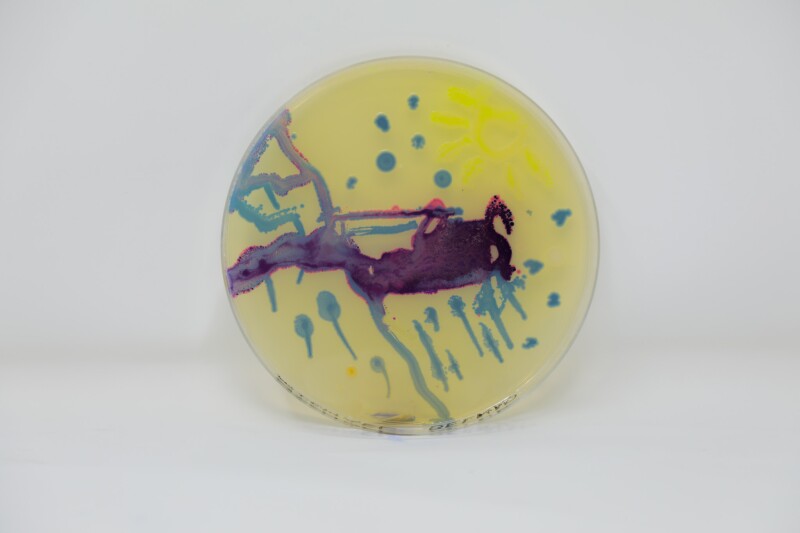
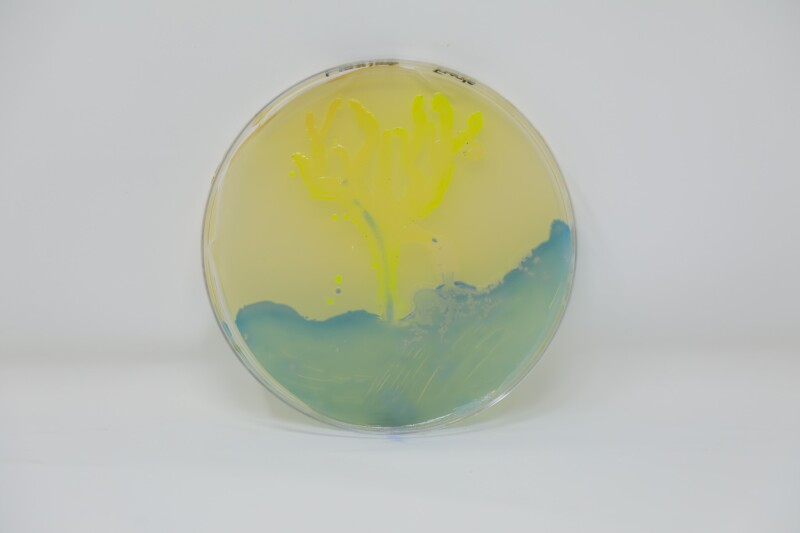
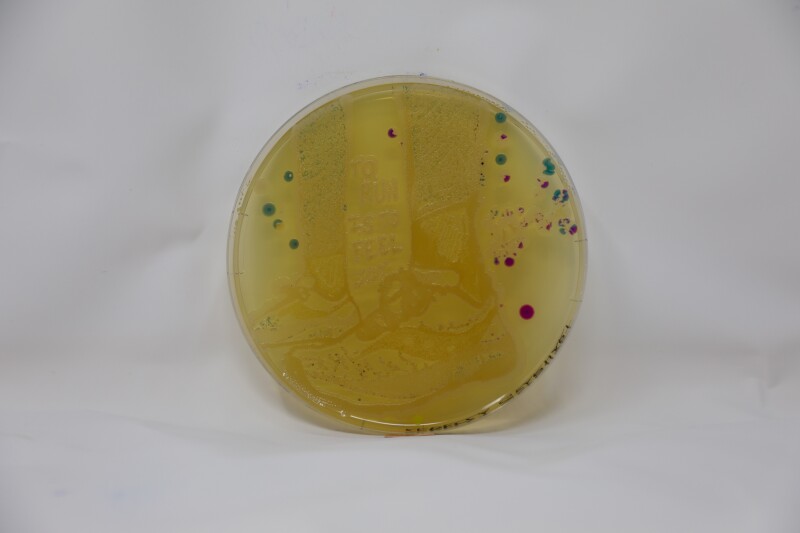
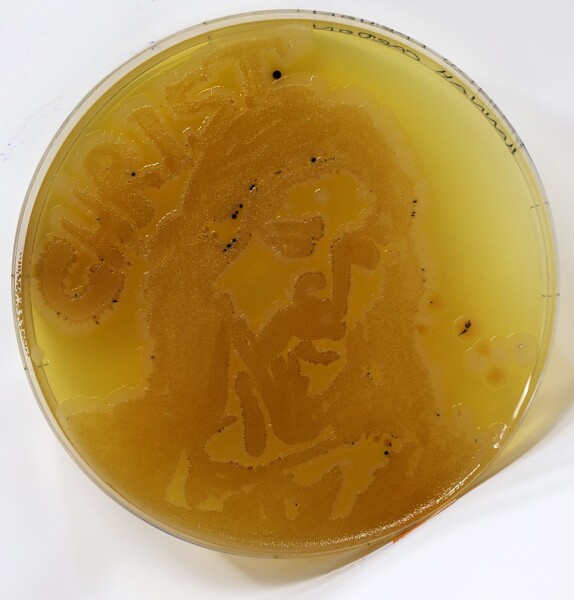
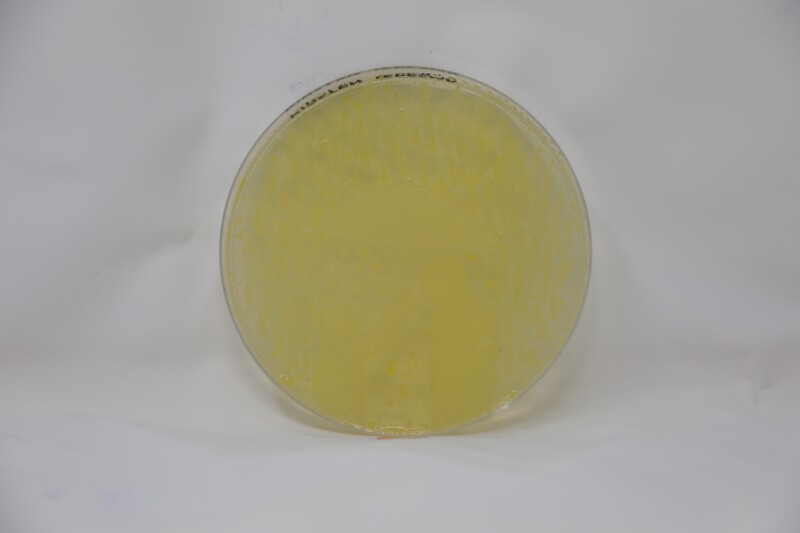
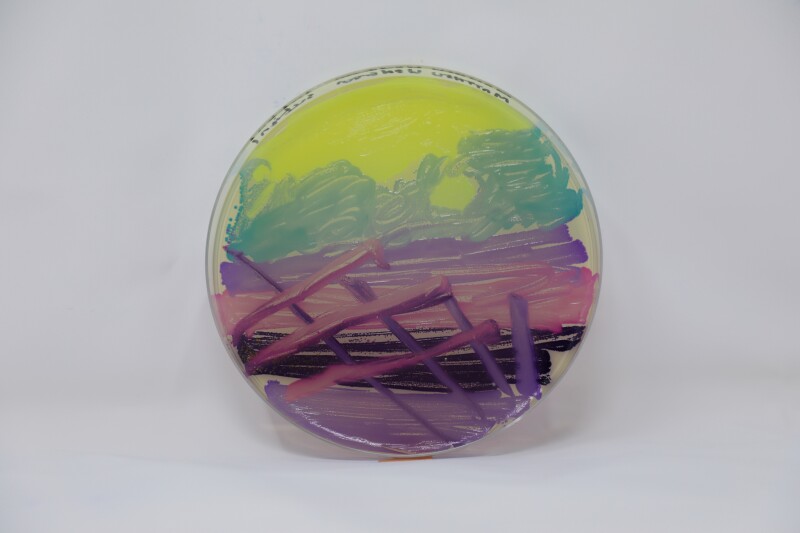
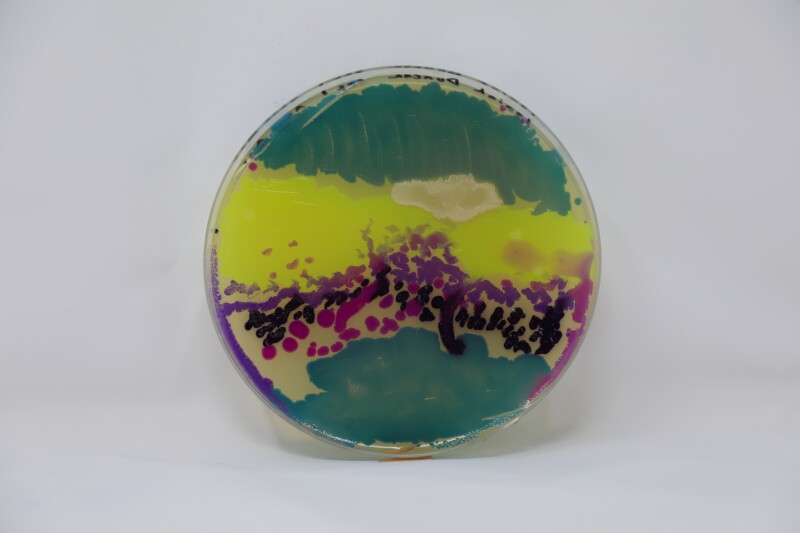
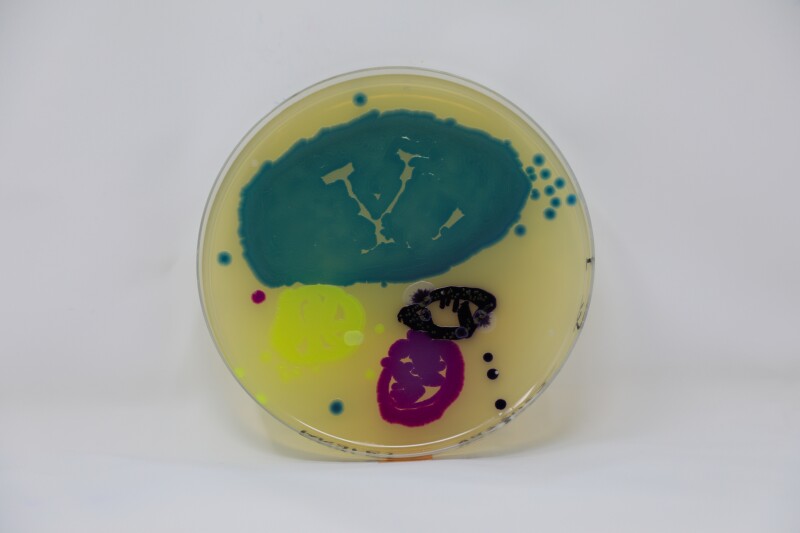
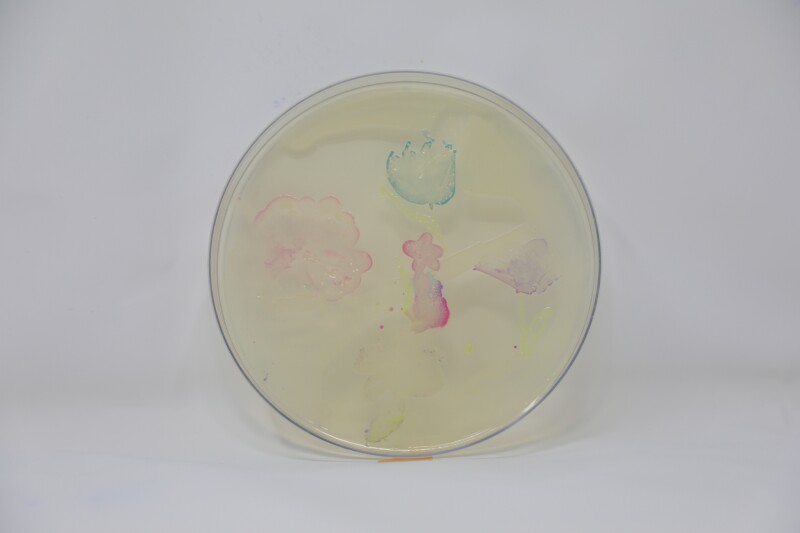
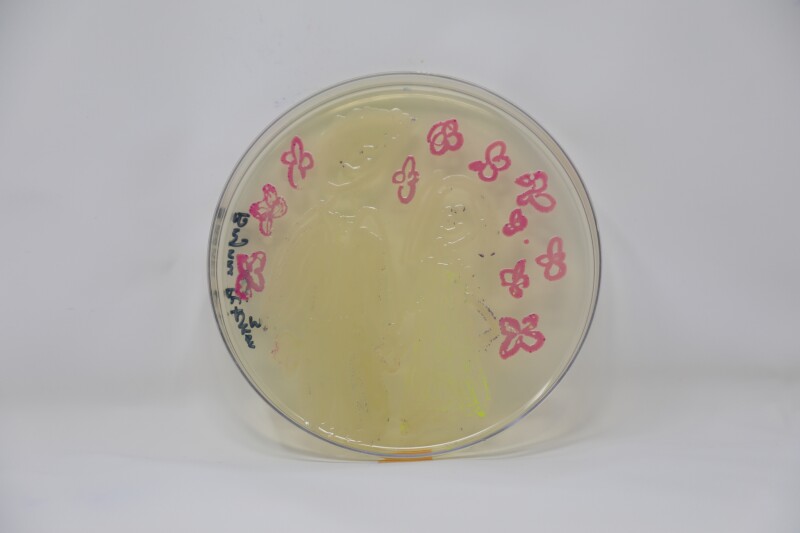
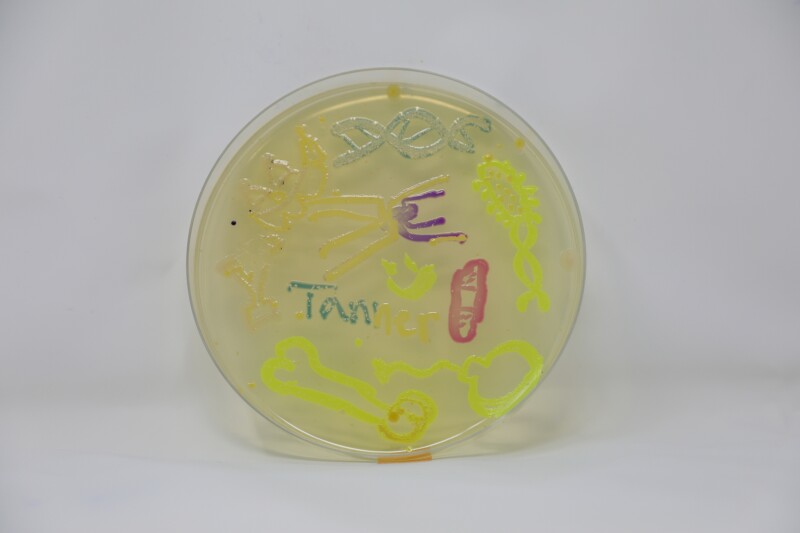
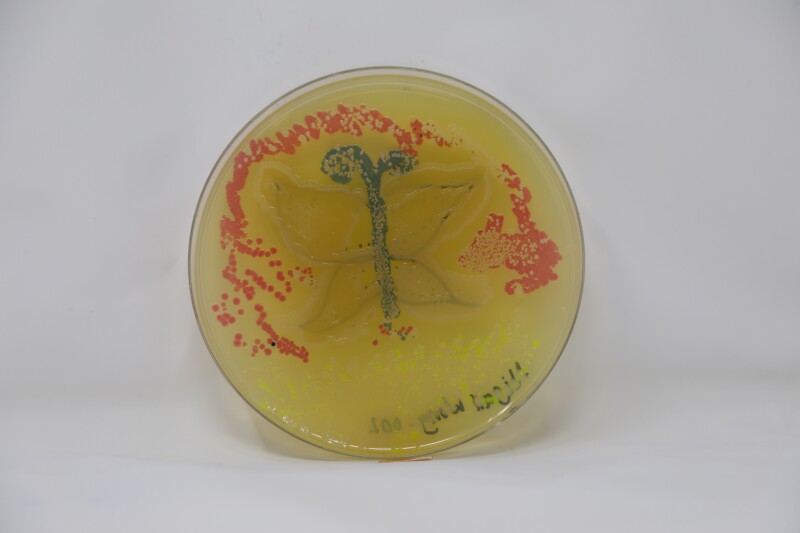
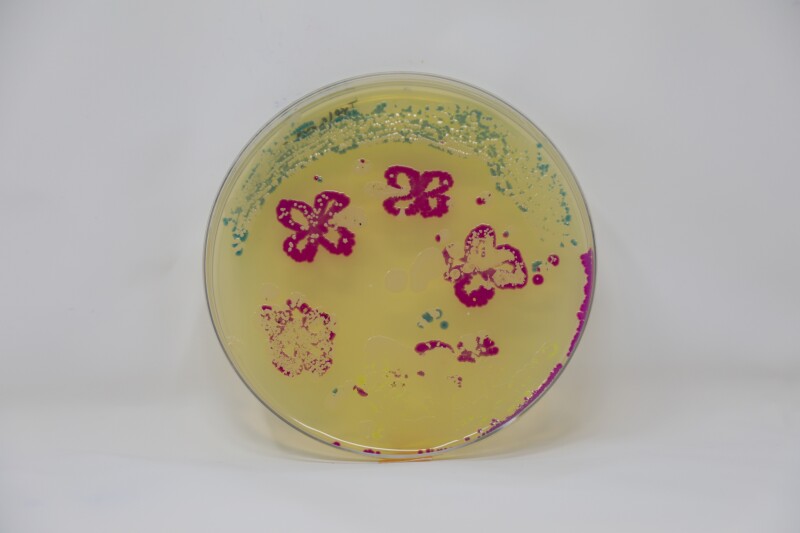
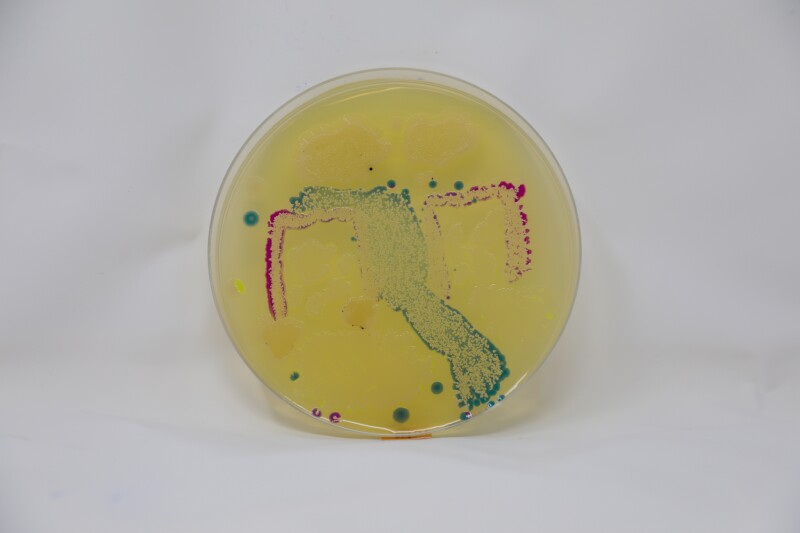
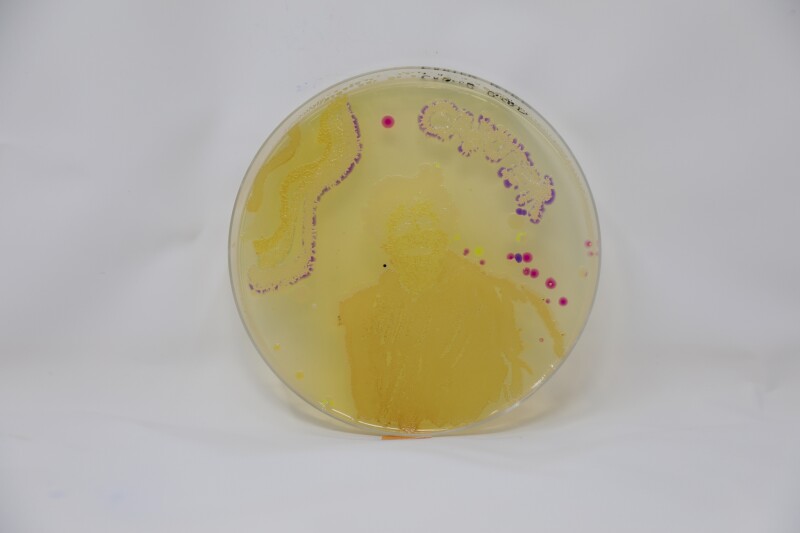
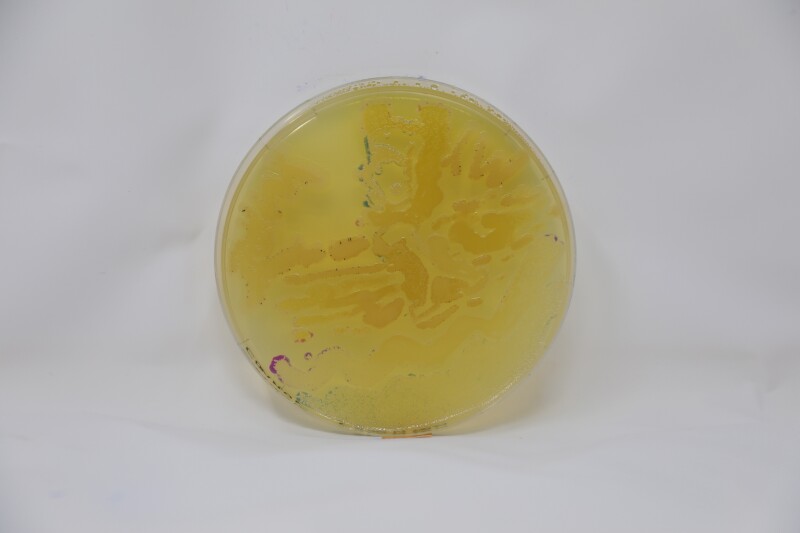
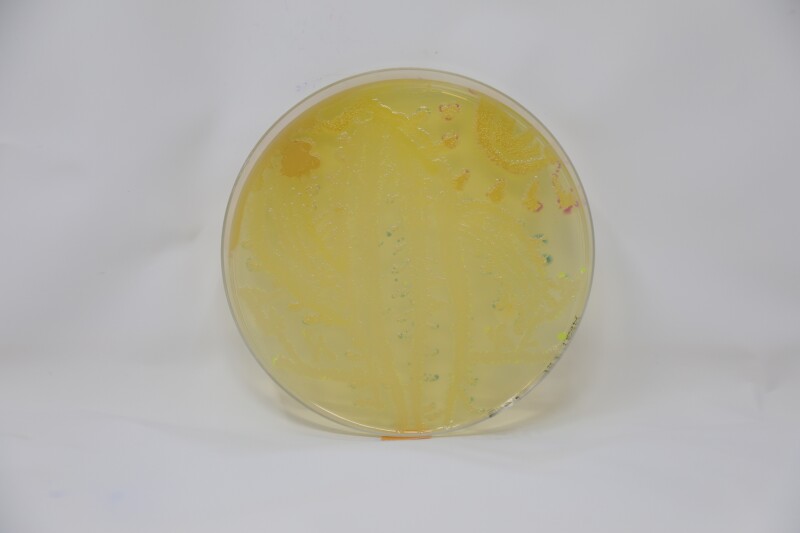
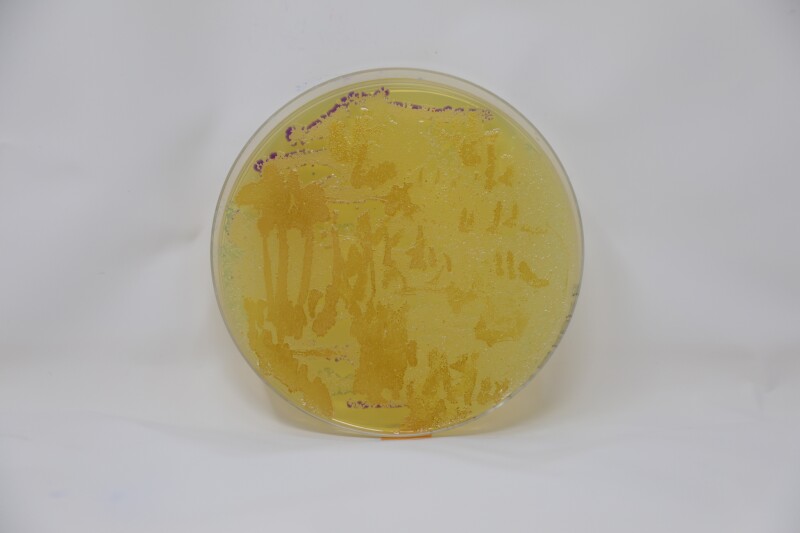
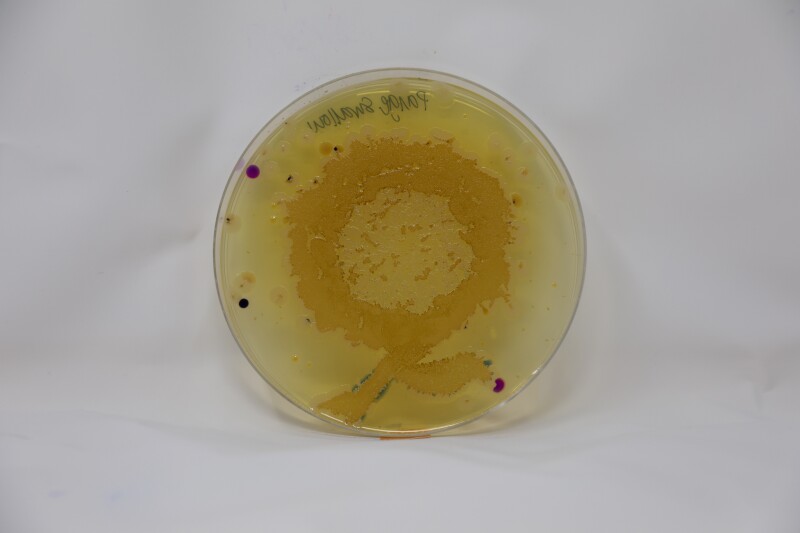
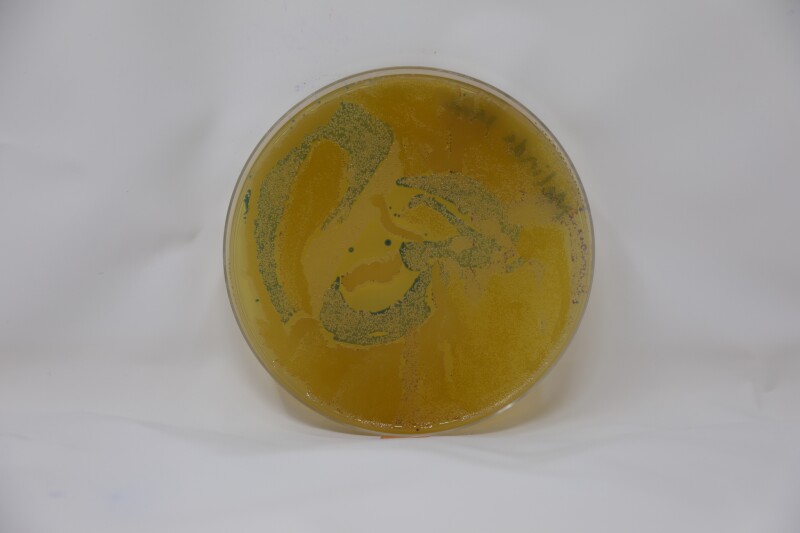
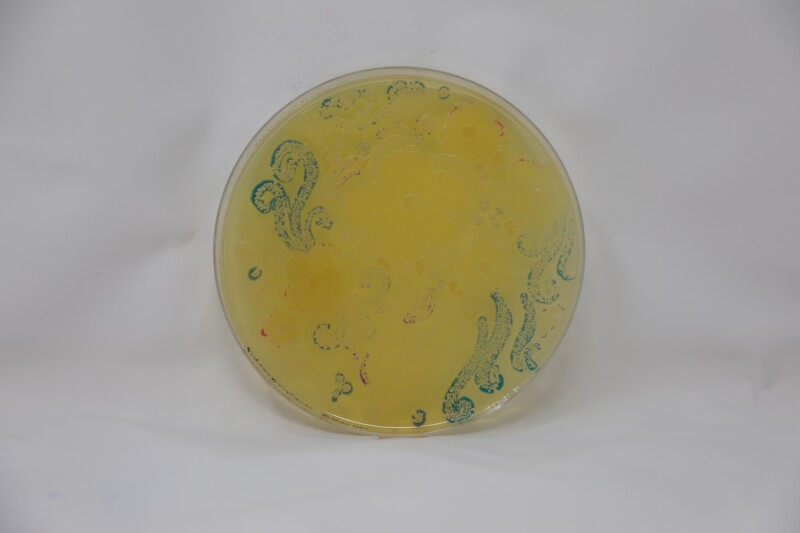
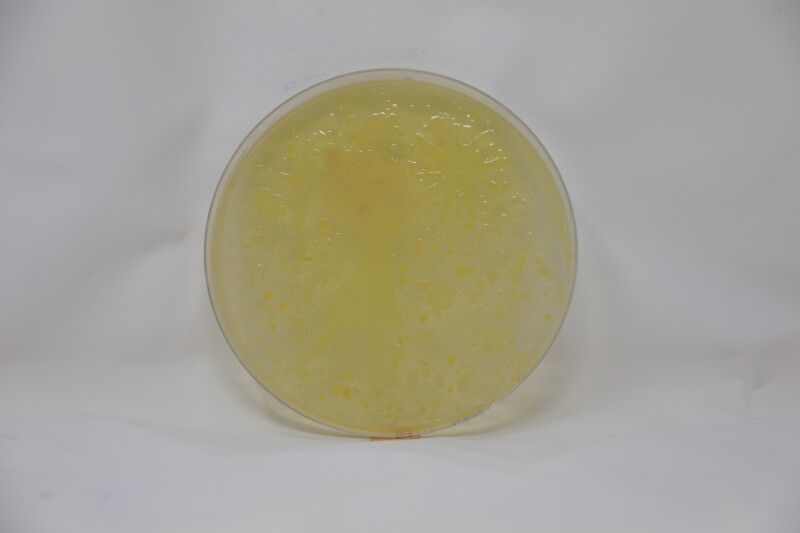
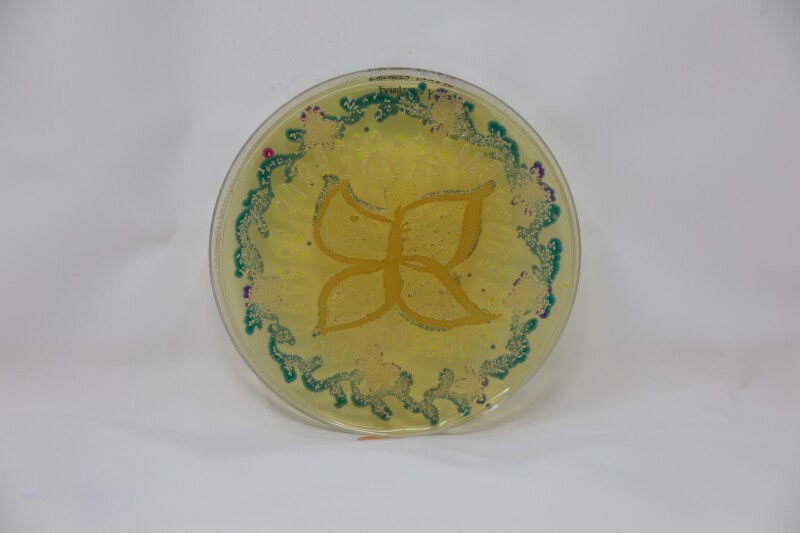

Agar Art
New Student Orientation
For BYU's New Student Orientation, incoming freshmen were invited to create a tiny masterpiece with bacteria that only comes to life after sitting in an incubator.
Better than invisible ink, harmless strains of E. coli are painted on agar's spongy surface. Scientists, artist, and curious enthusiasts trustingly layer their Petri dish canvas with six color options of the clear genetically modified bacteria created in the agar lab. The magic happens overnight while the bacteria feast on the stiff agar base (a jelly-like substance found in algae), bringing the vibrant colors of the genetically altered organisms to life. The image reveal is always a fun surprise.

Agar Art Contest
Every October the whole BYU community is invited to participate in our department's Agar Art Contest.
The theme for each contest allow participants to trace an image or freehand their design for the potential to win cash prizes, including $100 for first place, $50 for second place, and $25 for third place.
The art from the most recent contest, with the theme "What Brings You Joy?", is shown below.